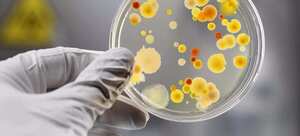

Кишкові захворювання у дітей: лікування та профілактика
Гострі кишкові інфекційні захворювання є найпоширенішими захворюваннями cеред дітей дошкільного та шкільного віку, особливо в літній період.
Причиною гострих кишкових інфекцій є кілька груп мікроорганізмів:
– бактерії (сальмонельоз, дизентерія, холера);
– віруси (ротавірус, ентеровірус);
– найпростіші (лямблії).
Джерелом кишкових інфекції є людина або тварина.
Провідні шляхи передачі:
– контактно-побутовий (через забруднені предмети, іграшки, соску, брудні руки тощо);
– харчовий (при вживанні в їжу недостатньо термічно оброблених чи недоброякісних продуктів харчування);
Вхідними воротами інфекції є шлунково-кишковий тракт. Мікроби, збудники кишкових інфекцій, можуть вражати не весь шлунково-кишковий тракт, а певні його відділи. Запальний процес в кожному такому відділі має свою медичну назву: запалення шлунка – гастрит, дванадцятипалої кишки – дуоденіт, тонкого кишківника – ентерит, товстого кишківника – коліт.
Типовим і найбільш характерним симптомом кишкової інфекції є пронос. Інші ознаки хвороби – нудота, блювота, біль в животі, підвищення температури тіла, відсутність апетиту, загальна слабкість – також є супутниками кишкових інфекцій.
Якщо з’являються будь які симптоми з нижченаведених, треба негайно звертатися за медичною допомогою до лікаря:
- якщо біль в животі не припиняється, або посилюється;
- через блювоту ви не можете дитину напоїти;
- більше 6 годин немає сечі;
- сухість язика, запалі очі, шкіра набула сіруватого відтінку;
- в калі є домішки крові;
- пронос припинився, але при цьому посилилася блювота, і (або) різко піднялася температура тіла, і (або) посилилися болі в животі.
Лікування кишкових інфекцій, перш за все полягає, у суворій дієті, заповненні втрат рідини і солей в організмі та терпінні – це майже завжди достатні умови для одужання (дотримання при цьому правил гігієни є невід’ємними правилами).
Найчастіше неважкі кишкові інфекції можна лікувати в домашніх умовах. При появі симптомів захворювання бажано зв’язатися зі своїм лікарем і попередити його, що ваша дитина захворіла, і докладно описати всю ситуацію.
В середньому для відпаювання дитини при гострій кишковій інфекції потрібно приблизно 100 мл на кожен кілограм маси тіла на добу (1000 мл для малюка вагою 10 кг), але може знадобитися і більше. Необхідно стежити, що у дитини була волога шкіра та сечовипуска́ння не рідше раз на три-чотири години.
Ідеальний розчин рідини при кишкової інфекції – сольові розчини. Вони продаються в аптеках або ж їх можна приготувати вдома: три чайні ложки цукру без верху плюс 1/2 чайної ложки солі на літр кип’яченої води.
Якщо маленька дитина відмовляється пити сольовий розчин, можна пити компот із сухофруктів або будь-яку рідину, яку дитина буде пити: хоч звичайну воду, хоч чай. Дітям на грудному вигодовуванні потрібно якомога частіше пропонувати грудне молоко, яке на 95% складається з води.
Поки у дитини блювота, йому взагалі немає сенсу давати їжу – тільки рідина. Коли блювота припиниться, то паралельно з відпаюванням ви можете пропонувати вже і їжу, але строго за апетитом! Не потрібно годувати насильно.
Діти на грудному вигодовуванні прекрасно обходяться грудним молоком і сольовими розчинами або компотом, при необхідності. Більш старші діти можуть починати з легко засвоюваних продуктів: фруктові киселі, сухарі з чаєм, галетне печиво, рисова каша, супи легкі – не на бульйоні тощо.
Основне правило – часто, але потроху.
Для видалення микробів та їх токсинів з пристінкового простору кишечника використовують різні сорбенти. При цьому важливо дотримуватися адекватні дозування препарату. Для зручності рекомендують використовувати лікарські препарати в формі гелів і сиропів, або подрібнювати таблетки у воді і давати на чайній ложці. Будь- який агресивний інфекційний агент, завдає шкоди корисній мікрофлорі травного тракту дитини. Для відновлення балансу корисних бактерій після припинення діареї необхідно застосування пробіотичних препаратів. Антибіотики при гострих кишкових інфекціях показані досить рідко, в основному це так звані інвазивні діареї, коли в калі з’являється кров. Ще їх застосовують в разі захворювання на холеру, а також позакишкові бактеріальними інфекціями, які призводять до розвитку діареї (пневмонія, середній отит і т.п.)
Отже, щоб уникнути гострих кишкових інфекцій у дітей, слід:

– суворо дотримуватися правил особистої гігієни, частіше і ретельно мити руки з милом, особливо перед їжею і після відвідин туалету;
– використовувати кип’ячену, бутильовану або воду гарантованої якості;
– не давати маленьким дітям некип’ячене розливне молоко, сирі яйця, використовувати для приготування їжі тільки свіжі продукти;
– овочі, фрукти, ягоди ретельно мити перед вживанням під проточною водопровідною водою, а для маленьких дітей – кип’яченою;
– використовувати тільки чисту упаковку (поліетилен, контейнери для харчових продуктів і т.п.);
– не купувати продукти харчування у випадкових осіб або в місцях несанкціонованої торгівлі;
– дотримуватися правил гігієни при приготуванні гарячих і холодних страв, терміни придатності та умови зберігання харчових продуктів, особливо швидкопсувних, сирі продукти і готову їжу слід зберігати окремо;
– ретельно прожарювати або проварювати продукти, особливо м’ясо, птицю, яйця і морські продукти;
– швидкопсувні продукти і готову їжу слід зберігати в холодильнику при температурі 2-6 С°;
– не змішувати свіжоприготовлену їжу з залишками від попереднього дня, але якщо готова їжа залишається на інший день, то перед вживанням її необхідно піддати термічній обробці (прокип’ятити або прожарити);
– не накопичувати сміття і харчові відходи, не допускайте появи мух і тарганів;
– постійно підтримувати чистоту в оселі і дотримуватися правил особистої гігієни.
Якщо, незважаючи на всі запобіжні заходи, все ж з’являються перші ознаки гострих кишкових інфекцій (нудота, багаторазова блювота, пронос, різкі болі в животі, болі в області шлунка), необхідно відразу звернутися за медичною допомогою. Тільки лікар може правильно призначити лікування, а також визначити необхідні заходи профілактики хвороби для осіб, що контактують з хворими. Самолікування небезпечно – для хворого, в результаті несвоєчасного, неправильного лікування хвороби можуть перейти у хронічні форми.
Автор статті: дитячий лікар-гастроентеролог Скалозубова І.Б.

